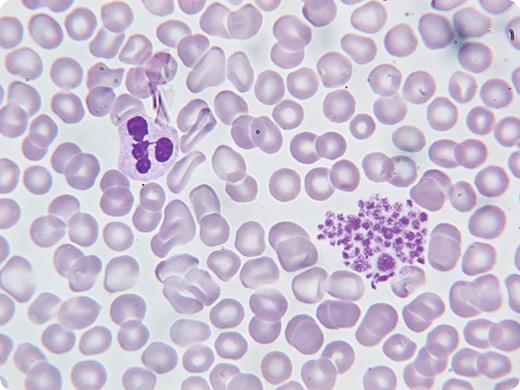

A 57-year-old retired farmer with no personal or family history of bleeding was found to have thrombocytopenia on routine blood work. He had a history of type 2 diabetes, hypertension, hyperlipidemia, and osteoarthritis. Medications included perindopril, insulin glargine, aspirin, metformin, ibuprofen, and oregano oil. Physical examination was normal.
His complete blood count (CBC) revealed a white blood cell count of 9.4 × 109/L, hemoglobin 160 g/L, and platelets of 10 × 109/L by automated counter. A peripheral blood film showed clumping of platelets (shown). A bone marrow aspirate and biopsy, initially performed to rule out myelodysplasia, was normal with normal-appearing megakaryocytes in adequate numbers. The original blood sample used ethylenediaminetetraacetic acid (EDTA) as an anticoagulant. A repeat CBC was done in sodium citrate and the platelet count was normal. The patient was diagnosed with pseudothrombocytopenia and no further treatment or blood work was required.
Unrecognized pseudothrombocytopenia may result in unnecessary diagnostic testing and clinical concern. A microscopic examination can identify platelet clumping and repeat CBC tests using a different anticoagulant can affirm the diagnosis.
A 57-year-old retired farmer with no personal or family history of bleeding was found to have thrombocytopenia on routine blood work. He had a history of type 2 diabetes, hypertension, hyperlipidemia, and osteoarthritis. Medications included perindopril, insulin glargine, aspirin, metformin, ibuprofen, and oregano oil. Physical examination was normal.
His complete blood count (CBC) revealed a white blood cell count of 9.4 × 109/L, hemoglobin 160 g/L, and platelets of 10 × 109/L by automated counter. A peripheral blood film showed clumping of platelets (shown). A bone marrow aspirate and biopsy, initially performed to rule out myelodysplasia, was normal with normal-appearing megakaryocytes in adequate numbers. The original blood sample used ethylenediaminetetraacetic acid (EDTA) as an anticoagulant. A repeat CBC was done in sodium citrate and the platelet count was normal. The patient was diagnosed with pseudothrombocytopenia and no further treatment or blood work was required.
Unrecognized pseudothrombocytopenia may result in unnecessary diagnostic testing and clinical concern. A microscopic examination can identify platelet clumping and repeat CBC tests using a different anticoagulant can affirm the diagnosis.
Many Blood Work images are provided by the ASH IMAGE BANK, a reference and teaching tool that is continually updated with new atlas images and images of case studies. For more information or to contribute to the Image Bank, visit www.ashimagebank.org.